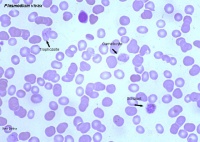

疟疾
疟疾(读音:nüè ji,英文:Malaria)俗称打摆子,是一种经按蚊叮咬而感染疟原虫所引起的虫媒传染病。中医称“正疟”、温疟。 临床以周期性寒战、发热、头痛、出汗和贫血、脾肿大为特征。儿童发病率高,大都于夏秋季节流行。疟原虫寄生于人体所引起的传染病。经疟蚊叮咬或输入带疟原虫者的血液而感染。不同的疟原虫分别引起间日疟、三日疟、恶性疟及卵圆疟。本病主要表现为周期性规律发作,全身发冷、发热、多汗,长期多次发作后,可引起贫血和脾肿大。疟疾是由疟原虫引起的寄生虫病,于夏秋季发病较多。在热带及亚热带地区一年四季都可以发病,并且容易流行。
症状[编辑 | 编辑源代码]
典型的疟疾多呈周期性发作,表现为间歇性寒热发作。一般在发作时先有明显的寒战,全身发抖,面色苍白,口唇发绀,寒战持续约10分钟至2小时,接着体温迅速上升,常达40℃或更高,面色潮红,皮肤干热,烦躁不安,高热持续约2~6小时后,全身大汗淋漓,大汗后体温降至正常或正常以下。经过一段间歇期后,又开始重复上述间歇性定时寒战、高热发作。
婴幼儿疟疾发热多不规则,可表现为持续高热或体温忽高忽低,在发热前可以没有寒战表现,或仅有四肢发凉、面色苍白等症状。婴幼儿疟疾高热时往往容易发生惊厥。
疟疾仍然是当今人类的最大杀手之一。“疟疾”一词在拉丁语中的含义是“坏的空气”,甚至古罗马人就意识到应避开某些沼泽地区的瘴气。但是,疟疾并不是由带病菌的空气、而是由不流动的水中所繁殖的蚊子造成的,正如罗纳德.罗斯在1892年怀疑的那样。
在疟疾患者体内发现了一种大小如红细胞的寄生虫。它是如何侵入人体的?罗斯设法 追踪这种寄生虫的生活史。它先存在于蚊子的胃内。在那儿繁殖后,这的幼虫侵入蚊子的唾液腺内。当蚊子叮人时,唾液中的寄生虫随之进入人体的血液中。几周之后,被感染的人就会出现疟疾特有的发热和寒战而病倒。这种发热呈一过性,并且反复发作。
罗斯的研究并没有治愈疟疾。一旦找到疟疾的病因,人们就能够设法消灭在沼泽里繁殖的蚊子。
只有雌性蚊子才叮人吸血,用来使这的卵健全成长。所以,只有雌性蚊子才会传播疟疾。
疟疾现在几乎已经在城市和城镇内绝迹的,但仍然流行于许多农村地区,特别是非洲,拉丁美洲和东南亚地区的农村。
奎宁是最古老的治疗疟疾的药物。作为唯一有效的药物,它一直使用了300年。预防仍然是对付疟疾最好武器。如今在疟疾流行的地区旅游,当有蚊子出没时,人们应该服用抗疟药,并使驱蚊剂来避免蚊子的叮咬。
疟疾(malaria)又名打摆子,是由疟原虫经蚊叮咬传播的污染病。临床上以周期性定时性发作的寒战、高热、出汗退热,以及贫血和脾大为特点。因原虫株、感染程度、免疫状况和机体反应性等差异,临床症状和发作规律表现不一。
疟疾是一很古老的疾病,远在公元2000年前《黄帝内经.素问》中即有《疟论篇》和《刺论篇》等专篇论述疟疾的病因、症状和疗法,并从发作规律上分为“日作”、“间日作”与“三日作”。然而,直到1880年法国人Laveran在疟疾病人血清中发现疟原虫;1897年国人Ross发现蚊虫与传播疟疾的关系,它的真正病因才弄清楚。
疟疾广泛流行于世界各地,据世界卫生组织统计,目前仍有92个国家和地区处于高度和中度流行,每年发病人数为1.5亿,死于疟疾者愈200万人。我国解放前疟疾连年流行,尤其南方,由于流行猖獗,病死率很高。解放后,全国建立了疟疾防治机构,广泛开展了疟疾的防治和科研工作,疟疾的发病率已显著下降。
病理[编辑 | 编辑源代码]
病原学[编辑 | 编辑源代码]
寄生于人体的疟原虫有四种:间日疟原虫(P.lasmodium)、恶性疟原虫(P.falciparum)、三日疟原虫(P.malarial)和卵形疟原虫(P.ovale)。我国以前二种为常见,卵形疟仅发现几例。各种脊椎动物(主要是禽类、鼠和猴猿类)的疟原虫有100多种,仅灵长类的疟原虫偶可感染人。
疟原虫的发育过程分两个阶段,即在人体内进行无性增殖、开始有性增殖和在蚊体内进行有性增殖与孢子增殖。四种疟原虫的生活史基本相同。
疟原虫在人体内的发育增殖 疟原虫在人体内发育增殖分为两个时期,即寄生于肝细胞内的红细胞外期和寄生于红细胞内的红细胞内期。
红细胞外期(exoeryghrocytic stage)当受染的雌性按蚊吮吸人血时,疟原虫子孢子随蚊唾液进入人体血循环,约半小时全部侵入肝细胞,速发型子孢子即进行裂体增殖,迟发型子孢子则进入休眠状态,在肝细胞内裂体增殖的疟原虫,经过5~40天发育成熟,胀破肝细胞逸出成千上万的裂殖子(meroxoite)进入血流,进入血流的裂殖子部分被吞噬细胞吞噬杀灭,部分侵入红细胞并在其内发育增殖,称为红细胞内期。迟发型子孢子经过休眠后,在肝细胞内增殖,释放裂殖子入血,即造成疟疾的复发。恶性疟疾无复发,是由于恶性疟疾子孢子无休眠期。
红细胞内期(eryghrocytic sgage)裂殖子侵入红细胞内,初期似戒指状,红色的核点,兰色环状的胞浆。称为环状体即小滋养体。环状体发育长大,胞浆可伸出不规则的伪足,以摄噬血红蛋白,此为阿米巴滋养体或大滋养体。未被利用的血红蛋白分解成正铁血红素颗粒蓄积在原浆内呈棕褐色,称为疟色素(malarial pigment)。大滋养体继续发育,其核与原浆进行分裂,形成裂殖体(schizont)。原虫种的不同裂殖体中裂殖子的数目也不一样,成熟后裂殖子数一般间日疟为12~24个,恶性疟为18~36个,三日疟和卵形疟为6~12个。成熟的裂殖体破裂,裂殖子逸出,一部分再侵入正常红细胞,一部分被吞噬细胞吞噬。释出的疟色素也被吞噬。
经过细胞内3~5次裂体增殖后,部分进入红细胞的裂殖子在红细胞内不再进行无性分裂,而逐渐发育成为雌或雄配子体。配子体在人体内可生存2~3个月,此期间如被雌性按蚊吸入胃内,则在蚊体内进行有性增殖。
疟原虫在蚊体内的发育雌性按蚊叮咬疟疾患者,雌、雄配子体进入蚊胃内,雄配子体的核很快分裂,并由胞浆向外伸出4~8条鞭毛状细丝,碰到雌配子体即进入,雌雄结合成为圆形的合子(zygote)。合子很快变成能蠕动的合子(pokinete)。它穿过胃壁,在胃壁外弹力纤维膜下发育成囊合子,囊内核和胞浆进行孢子增殖。孢子囊成熟,内含上万个子孢子,囊破裂子孢子逸出,并进入唾液腺,待此按蚊叮人时子孢子即随唾液进入人体。
流行病学[编辑 | 编辑源代码]
传染源 疟疾病人及带虫者是疟疾的传染源。且只有末梢血中存在成熟的雌雄配子体时才具传染性。配子体在末梢血液中的出现时间、存在时间及人群的配子体携带率,随虫种不同而异。如间日疟在无性体出现2~3天之后出现配子体;而恶性疟则在无性体出现7~10天后。复发者出现症状时血中即有成熟的配子体。疟区的轻症患者及带虫者,没有明显临床症状,血中也有配子体。这类人员也可成为传染源。
传染期:间日疟1~3年;恶性疟1年以内;三日疟3年以上,偶达数十年;卵形疟2~5年。
猴疟偶可感染人类,成为动物传染源。
传播途径 疟疾的自然传播媒介是按蚊。按蚊的种类很多,可传播人疟的有60余种。据其吸血习性、数量、寿命及对疟原虫的感受性,我国公认中华按蚊、巴拉巴蚊、麦赛按蚊、雷氏按蚊、微小按蚊、日月潭按蚊及萨氏按蚊等七种为主要传疟媒介按蚊。人被有传染性的雌性按蚊叮咬后即可受染。
偶尔输入带疟原虫的血液或使用含疟原虫的血液污染的注射器也可传播疟疾。罕见通过胎盘感染胎儿。
人群易感性 人对疟疾普遍易感。多次发作或重复感染后,再发症状轻微或无症状,表明感染后可产生一定免疫力。高疟区新生儿可从母体获得保护性IgG。但疟疾的免疫不但具有种和株的特异性,而且还有各发育期的特异性。其抗原性还可连续变异,致宿主不能将疟原虫完全清除。原虫持续存在,免疫反应也不断发生,这种情况称带虫免疫(premunition)或伴随免疫。
人群发病率因流行程度及机体状况而不同。高疟区,成人发病率较低,儿童和外来人口发病率较高。婴儿血中胎儿血红蛋白不适于疟原虫发育,故先天疟疾和婴儿疟疾少见。某些先天性因素,如地中海贫血、卵形红细胞血症、G—6-P脱氢酶缺乏者等对疟原虫有抗性。血型因素,东非人为Duffy血型,西非人则多为FyFy型,Duffy血型抗原为间日疟原虫的入侵受体,所以西非黑人对间日疟不易感,而东非间日疟一直流行。此外营养好的儿童发生重症疟疾者较瘦弱者多。
流行特征 疟疾分布广泛,北纬60°至南纬30°之间,海拔2771米高至海平面以下396米广大区域均有疟疾发生。我国除青藏高原外,遍及全国。一般北纬32°以北(长江以北)为低疟区;北纬25°~32°间(长江以南,台北、桂林,昆明连线以北)为中疟区;北纬25°以南为高疟区。但实际北方有高疟区,南方也有低疟区。间日疟分布最广;恶性疟次之,以云贵、两广及海南为主;三日疟散在发生。
本病流行受温度、湿度、雨量以及按蚊生长繁殖情况的影响。温度高于30℃低于16℃则不利于疟原虫在蚊体内发育.适宜的温度、湿度和雨量利于按蚊孳生。因此,北方疟疾有明显季节性,而南方常终年流行。疟疾通常呈地区性流行。然而,战争,灾荒,易感人群介入或新虫株导入,可造成大流行。
发病原理与病理改变[编辑 | 编辑源代码]
疟疾是由疟原虫引起的疾病。由于被寄生的肝细胞周围没有明显炎症反应,推测红外期不引起宿主临床症状。从疟疾症状发作与疟原虫红内期成熟时间一致情况看,认为系疟原虫在红细胞内摄噬血红蛋白产生代谢产物及疟色素,当裂殖体成熟后胀破红细胞,随同裂殖子一起进入血流,作用于体温调节中枢引起发热及其他有关症状。不同种的原虫裂体增殖时间不一致,因而临床发作周期也不一致,一般间日疟和卵形疟为隔日一次,三日疟隔两天一次,恶性疟由于原虫发育不整齐,遂使发作不规律,且恶性疟原虫的红细胞内期裂体增多在内脏微血管内进行,易致内脏损害。
疟疾的发作还与原虫的数量有关,导致发热所需每立方毫米血内最低原虫数目,称为发热阈值。间日疟为10~500;恶性疟为500~1300;三日疟140。变化幅度与个体的耐受力与免疫力有关。
新近研究认为子孢子侵入肝细胞是子孢子内的分泌物起动,并与肝细胞膜的位点特异粘附主动入侵的过程。裂殖子钻入红细胞也是特异受体介导下完成。机体为清除疟原虫,体液和细胞免疫均参与其过程。尤其是巨噬细胞在疟原虫诱导下产生肿瘤坏死因子(TNF),TNF增强巨噬细胞活性,使吞噬疟原虫,吞噬过程中又促进释放活性氧,活性氧再杀灭疟原虫。另一方面TNF及活性氧又引起机体组织器官的损伤和典型的临床症状。
凶险型疟疾的发病原理 过去提出的栓塞说;炎症说;DIC说均属推测。近年来的深入研究认为系寄生疟原虫的RBC与宿主、内脏血管内皮细胞特异粘附导致微血管床阻塞、组织缺氧,以及免疫活性细胞释放的TNF等细胞活素、活性氧共同作用,造成组织器官严重的病理损害。
病理变化 疟疾的病理变化主要由单核巨噬细胞增生所致。在脾内大量吞噬细胞吞噬含原虫的红细胞、及被原虫破坏的红细胞碎片与疟色素,因而患者脾肿大,肿大的脾脏质硬、包膜厚;切面充血,马氏小体不明显。显微镜下可见大量含疟原虫的红细胞及疟色素;反复发作者网状组织纤维化,因而病愈后脾肿不能缩小。肝脏轻度肿大,肝细胞混浊肿胀与变性,小叶中心区尤甚。Kupffer细胞大量增生,内含疟原虫及疟色素。高疟区患者有脾脏巨大,血清IgM及疟疾抗体升高,但其疟原虫数不多,抗疟治疗有效,称此为热带巨脾综合症(Tropical splenomegaly syndrome)。可能是与遗传有关的异常免疫反应。
贫血 疟原虫破坏红细胞因虫种差异及疟原虫侵犯红细胞的类型不一而不同。恶性疟原虫繁殖迅速,且侵犯不同年龄的红细胞,所以短期内即有10%的红细胞破坏。因而贫血发生早而显著。间日疟常侵犯网织红细胞,受染红细胞不超过2%,故贫血较轻。三日疟原虫侵犯衰老的红细胞,破坏不超过1%,贫血常不显著。事实上红细胞破坏的数量往往几倍于受染红细胞数,这可能是疟原虫的抗原成份沾染了正常红细胞,而导致机体免疫识别有关。恶性疟疾时红细胞大量破坏,发生DIC,可出现溶血性黄疸。
凶险发作可致脑组织充血、水肿;大脑白质内散在出血点、充血;软脑膜显著充血水肿,重者沟回变浅。显微镜下毛细血管充血,内含大量染疟原虫的红细胞及不含虫而聚集的红细胞。还可见环形出血灶、Durcl肉芽肿、局灶性脱鞘和退行性病变。
其它器官如:骨髓、肾、胃肠、肺、心、肾上腺等亦有不同程度的吞噬细胞增生,并可见吞噬有含疟原虫的红细胞和疟色素,毛细血管内有含疟原虫的红细胞,甚者微血管阻塞,内皮脱落、变性坏死等。
临床诊断[编辑 | 编辑源代码]
临床表现[编辑 | 编辑源代码]
潜伏期 从人体感染疟原虫到发病(口腔温度超过37.8℃),称潜伏期。潜伏期包括整个红外期和红内期的第一个繁殖周期。一般间日疟、卵形疟14天,恶性疟12天,三日疟30天。感染原虫量、株的不一,人体免疫力的差异,感染方式的不同均可造成不同的潜伏期。温带地区有所谓长潜伏期虫株,可长达8~14个月。输血感染潜伏期7~10天。胎传疟疾,潜伏期就更短。有一定免疫力的人或服过预防药的人,潜伏期可延长。
间日疟(tertian malaria)多急起,复发者尤然。初次感染者常有前驱症状,如乏力、倦怠、打呵欠;头痛,四肢酸痛;食欲不振,腹部不适或腹泻;不规则低热。一般持续2~3天,长者一周。随后转为典型发作。分为三期。
发冷期 骤感畏寒,先为四肢末端发凉,迅觉背部、全身发冷。皮肤起鸡皮疙瘩,口唇,指甲发绀,颜面苍白,全身肌肉关节酸痛。进而全身发抖,牙齿打颤,有的人盖几床被子不能制止,持续约10分钟,乃至一小时许,寒战自然停止,体温上升。此期患者常有重病感。
发热期 冷感消失以后,面色转红,紫绀消失,体温迅速上升,通常发冷越显著,则体温就愈高,可达40℃以上。高热患者痛苦难忍。有的辗转不安,呻呤不止;有的谵妄,撮空,甚至抽搐或不省人事;有的剧烈头痛.顽固呕吐。患者面赤.气促;结膜充血;皮灼热而干燥;脉洪而速;尿短而色深。多诉说心悸,口渴,欲冷饮。持续2-6小时,个别达10余小时。发作数次后唇鼻常见疱疹。
出汗期 高热后期,颜面手心微汗,随后遍及全身,大汗淋漓,衣服湿透,约2~3小时体温降低,常至35.5℃。患者感觉舒适,但十分困倦,常安然入睡。一觉醒来,精神轻快,食欲恢复,又可照常工作。此刻进入间歇期。
整个发作过程约6~12小时,典型者间歇48小时又重复上述过程。一般发作5~10次,因体内产生免疫力而自然终止。
多数病例早期发热不规律,可能系血内有几批先后发育成熟的疟原虫所致。部分病人在几次发作后,由于某些批疟原虫被自然淘汰而变得同步。
数次发作以后患者常有体弱,贫血,肝脾肿大。发作次数愈多,脾大,贫血愈著。由于免疫力的差异或治疗的不彻底,有的病人可成慢性。
三日疟(quartan malaria) 发作与间日疟相似,但为三日发作一次,发作多在早晨,持续4~6小时。脾大贫血较轻,但复发率高,且常有蛋白尿,尤其儿童感染,可形成疟疾肾病。三日疟易混合感染,此刻病情重很难自愈。
卵形疟(ovale malaria) 与间日疟相似,我国仅云南及海南有个别报道。
恶性疟(subtertian malaria) 起病缓急不一,临床表现多变,其特点:
①起病后多数仅有冷感而无寒战;②体温高,热型不规则。初起进常呈间歇发热,或不规则,后期持续高热,长达20余小时,甚至一次刚结束,接着另一次又发作,不能完全退热;③退热出汗不明显或不出汗;④脾大、贫血严重;⑤可致凶险发作;⑥前驱期血中即可检出疟原虫;无复发。
凶险型疟疾 88.3~100%由恶性疟疾引起,偶可因间日疟或三日疟发生。在暴发流行时5岁以下的幼儿,外来无免疫力的人群发生率可成20倍的增长;即便当地人群,治疗不及时也可发生。临床上可观察患者原虫数量作为监测项目,若厚片每视野达300~500个原虫,就可能发生;如每视野600个以上则极易发生。临床上主要有下列几种类型。
脑型 最常见。其特点:①常在一般寒热发作2~5天后出现,少数突然晕倒起病;②剧烈头痛,恶心呕吐;③意识障碍,可烦躁不安,进而嗜睡,昏迷;④抽搐,半数患者可发生,儿童更多;⑤如治疗不及时,发展成脑水肿,致呼吸、循环或肾功衰竭;⑥查体有脾大,2/3的患者在出现昏迷时肝脾已肿大;贫血、黄疸、皮肤出血点均可见;神经系统检查,脑膜刺激征阳性,可出现病理反射;⑦实验室检查:血涂片可查见疟原虫。腰椎穿刺脑脊液压力增高,细胞数常在50个/ um以下,以淋巴细胞为主;生化检查正常。
胃肠型 除发冷发热外,尚有恶心呕吐、腹痛腹泻,泻水样便或血便,可似痢疾伴里急后重。有的仅有剧烈腹痛,而无腹泻,常被误为急腹症。吐泻重者可发生休克、肾衰而死。
过高热型 疟疾发作时,体温迅速上升达42℃或更高。患者气迫,谵妄、抽搐,昏迷,常于数小时后死亡。
黑尿热 是一种急性血管溶血,并引起血红蛋白和溶血性黄疸,重者发生急性肾功能不全。其原因可能是自身免疫反应,还可能与G—6-P脱氢酶缺乏有关。临床以骤起、寒战高热、腰痛、酱油色尿、排尿刺痛感,以及严重贫血、黄疸,蛋白,管型尿为特点。本病地理分布与恶性疟疾一致,国内除西南和沿海个别地区外,其他地区少见。
疟疾并发症[编辑 | 编辑源代码]
疟疾的初期病征与感冒相似有间歇性发烧发冷和头痛,并可导致并发症如肺水肿、肝肾衰竭贫血、甚至昏迷。
后期如不经过治疗有可能发生严重并发症如脑型疟、黑热尿,甚至导致死亡
恶性疟热型疟疾能引起严重的并发症并波及肾、肝、脑血液。
其它疟疾[编辑 | 编辑源代码]
输血疟疾 潜伏期7~10日,临床症状与蚊传者相似。只有红细胞内期,故治疗后无复发。
婴幼儿疟疾 临床多不典型,或低热,或弛张热,或高热稽留,或不发热。热前常无寒战,退热也无大汗。多有吐泻、抽搐或微循环障碍。病死率高。检查有脾大、贫血、血中有大量疟原虫。
孕妇疟疾 易致流产、早产、死产、即便生下婴儿也可成先天疟疾,成活率极低。所以妊娠疟疾应及进治疗。
再燃和复发 疟疾发作数次后,由于机体产生的免疫力或经彻底治疗而停发作,血中原虫也被彻底消灭,但迟发性子孢子经过一段休眠期的原虫增殖后再入血流并侵入红细胞,引起发作,称为复发。而复发主要见于间日疟和三日疟。再燃指经治疗后临床症状受到控制,但血中仍有疟原虫残存,当抵抗力下降时,疟原虫增裂临床症状出现。再燃多在初发后3个月内。复发则不一,间日疟复发多在一年内;三日疟在二年内,个别达几十年还可复发。
实验室检查[编辑 | 编辑源代码]
血象 红细胞和血红蛋白在多次发作后下降,恶性疟尤重;白细胞总数初发时可稍增,后正常或稍低,白细胞分类单核细胞常增多,并见吞噬有疟色素颗粒。
疟原虫检查
骨髓涂片染色查疟原虫,阳性率较血片高。
血清学检查 抗疟抗体一般在感染后2~3周出现,4~8周达高峰,以后逐渐下降。现已应用的有间接免疫荧光、间接血凝与酶联免疫吸附试验等,阳性率可达90%。一般用于流行病学检查。
诊断[编辑 | 编辑源代码]
流行病学 有在疟疾流行区居住或旅行史,近年有疟疾发作史或近期曾接受过输血的发热患者都应被怀疑。
临床表现 典型的周期性寒战、发热、出汗可初步诊断。不规律发热,而伴脾、肝肿大及贫血,应想到疟疾的可能。凶险型多发生在流行期中,多急起,高热寒战,昏迷与抽搐等。流行区婴幼儿突然高热、寒战、昏迷,也应考虑本病。
实验室检查 主要是查找疟原虫,通常找到即可确诊。血片找疟原虫应当在寒战发作时采血,此时原虫数多、易找。需要时应多次重复查找。并一定要做厚血片寻找。如临床高度怀疑而血片多次阴性可做骨髓穿刺涂片查找疟原虫。
治疗性诊断 临床表现很象疟疾,但经多次检查未找到疟原虫。可试用杀灭红内期原虫的药物(如氯喹),治疗48小时发热控制者,可能为疟疾。但注意耐氯喹虫株。
鉴别诊断[编辑 | 编辑源代码]
一般非典型疟疾应与下列疾病相鉴别
败血症 疟疾急起高热,热型稽留或弛张者,类似败血症。但败血症全身中毒症状重;有局灶性炎症或转移性化脓病灶;白细胞总数及中性粒细胞增高;血培养可有病原菌生长。
钩端螺旋体病 本病流行多在秋收季节,与参加秋收接触疫水有密切关系。临床典型症状“寒热酸痛一身乏,眼红腿痛淋巴大”可供鉴别。
丝虫病 急性丝虫病有时需与疟疾鉴别,鉴别主要依离心性淋巴管炎,血片中找到微丝蚴。
伤寒、副伤寒 一般起病不急,持续高热,常无寒战及大汗,有听力减退,相对缓脉,玫瑰疹,白细胞减少,嗜酸性粒细胞消失,肥达反应阳性,血或骨髓培养阳性等特点,不难鉴别。
急性血吸虫病 来自流行区,近期接触过疫水,有皮疹,嗜酸性粒细胞明显增高,血吸虫皮试阳性,大便孵化阳性,即可确诊为血吸虫病。
脑型疟疾 本病发生易与流行性乙型脑炎、中毒性痢疾、中暑相混淆。通常要仔细反复查找疟原虫。毒痢还应做粪常规、培养。一时弄不清可先用抗疟药治疗以等待结果。
治疗[编辑 | 编辑源代码]
基础治疗 ①发作期及退热后24小时应卧床休息;②要注意水份的补给,对食欲不佳者给予流质或半流质饮食,至恢复期给高蛋白饮食;吐泻不能进食者,则适当补液;有贫血者可辅以铁剂;③寒战时注意保暖;大汗应及时用干毛巾或温湿毛巾擦干,并随时更换汗湿的衣被,以免受凉;高热时采用物理降温,过高热患者因高热难忍可药物降温;凶险发热者应严密观察病情,及时发现生命体征的变化,详细记录出入量,做好基础护理;④按虫媒传染病做好隔离。患者所用的注射器要洗净消毒。
病原治疗的目的是既要杀灭红内期的疟原虫以控制发作,又要杀灭红外期的疟原虫以防止复发,并要杀灭配子体以防止传播。
控制发作 磷酸氯喹(Chloropuine phosphate)简称氯喹,每片0.25g(基质0.15g)。第一天4片,6小时后再服2片,第2、3天每天2片,共计10片。治疗间日疟及三日疟第1天4片已足;治疗半免疫者单剂4片即可。该药吸收快且安全,服后1~2小时血浓度即达高峰;半衰期120小时;疗程短;毒性较小,是目前控制发作的首选药。部分患者服后有头晕、恶心。过量可引起心脏房室传导阻滞、心率紊乱、血压下降。禁忌不稀释静注及儿童肌肉注射。尿的酸化可促进其排泄。严重中毒呈阿斯综合征者,采用大剂量阿托品抢救或用起搏器。值得注意的是恶性疟疾的疟原虫有的对该药已产生抗性。 盐酸氨酚喹啉(Amodiaquine dihydrochloridum)作用与氯喹相似。每片0.25g(基质0.2g),第1天3片,第2、3天各2片。 哌喹(Piperaquine)及磷酸哌喹(Piperaquine phosphate)本品作用类似氯喹,半衰期9天,为长效抗疟药。哌喹每片含基质0.3g,磷酸哌喹每片0.25g(基质0.15g),口服首剂基质0.6g,8~12小时后再服0.3g(恶性疟0.6g)。哌喹须经胃酸作用成盐酸盐后才易吸收。磷酸哌喹吸收快,味苦。耐氯喹的虫株对本品仍敏感。
羟基哌基(Hydroxypiperaquine)及磷酸羟基哌喹(Hydroxypiperaquine phosphate)与哌喹类同,但吸收较快,半衰期2-3天。三天疗法恶性疟各服基质0.6、0.6、0.3g;良性疟疾各服0.6、0.3、0.3g。较哌喹类更适用。
硫酸奎宁(Quinine sulfate) 本品系金鸡钠树皮中的一种生物碱。抗疟作用与氯喹大致相同,除较迅速杀灭红内期原虫外,还有退热作用。但该药半衰期短(10小时),味苦;对中枢有抑制作用,表现为头昏,耳呜和精神不振;对心脏有全面抑制作用,静注可出现血压下降;对子宫能增加其收缩力,可引起流产;因此该药仅用于抗氯喹的恶性疟疾及重症病例的抢救。片剂每片0.3或0.12g,口服第1~2天0.45~0.6g,每天3次,第3~7天0.3~0.6g,每天2次。二盐酸奎宁仅在凶险疟疾时考虑使用。***盐酸甲氟喹(Meflquine hydrocloridum)适用于治疗各型疟疾及有抗性的病例。一次顿服4~6片(1~1.5g)。
硝喹(Nitro quinum,CI679) 本品对各种疟疾及抗氯喹虫株均有效。每片基质12.5mg,常与氨苯砜复方,各含12.5mg。口服每天4片,连服3天;3岁以下服1/4片。72小时方能控制症状,故作用较慢。
青蒿素 该药作用于原虫膜系结构,损害核膜、线粒体外膜等而起抗疟作用。其吸收特快,很适用于凶险疟疾的抢救。总剂量2.5g,首次1.0g,6小时后0.5g,第2、3日各0.5g。因排泄迅速,故易复发。蒿甲醚,肌注首剂0.2g,第2~4日各0.1g。
其它新药 磷酸咯啶(Pyracrine phosphate)每片0.1g,首剂3片,以后2片,每日两次,疗程2日。磷酸咯萘啶(Pyronaridine phosphas)疗程2日,各服基质0.8、0.4g。间氮丫啶(Azacrine)疗程3日,各服0.6、0.3、0.3g。半免疫者可服单剂0.6g。
针刺疗法 于发作前两小时治疗可控制发作,系调动了体内免疫反应力。穴位有大椎、陶道、间使、后溪,前两穴要使针感向肩及尾骨方向放散,间歇提插捻转半小时。疟门穴,承山穴单独针刺有同样效果。
中医药 祖国医学认为病因是外感暑温疟邪。分为正疟、瘴疟、久疟。正疟相当于慢性复发疟疾。正疟主张和解少阳,祛邪上疟,应用小柴胡汤加减(柴胡、黄苓、党参、陈皮、半夏、甘草)。瘴疟认为需清热、保津、截疟,主张给生石膏、知母、玄参、麦冬、柴胡、常山,随症加减。久疟者需滋阴清热,扶养正气以化痰破淤、软坚散结,常用青蒿别甲煎;何人饮;别甲煎丸等。民间常用单方验方,如马鞭草1-2两浓煎服;独头大蒜捣烂敷内关;酒炒常山、槟榔、草果仁煎服等。均为发作前2~3小时应用。
恶性疟原虫的抗药性
凡氯喹2.5g(基质1.5g)总量分3日服,未能消除无性生殖原虫,或1月内再燃者,称为抗性。对有抗性者应选用甲氯喹、青蒿素或联合用药。
其他治疗药物
青蒿素
分子式:C15H22O5
分子量:282.33
无色针状晶体,味苦。
在丙酮、醋酸乙酯、氯仿、苯及冰醋酸中易溶,在乙醇和甲醇、乙醚及石油醚中可溶解,在水中几乎不溶。
熔点:156-157℃ ( 水煎后分解)
防止复发和传播
磷酸伯氨喹啉(Primaquine phosphate,简称伯喹) 本品能杀灭红细胞外期原虫及配子体,故可防止复发和传播。每片13.2mg(基质7.5mg),可每日服3片,连续8天,或每日片,4日疗程。恶性疟疾为防止传播也可服伯喹,顿服4片或1日片,连续2~3日以消灭配子体。本品过量或者红细胞缺乏G—6-PD,则易致溶血反应。伯喹可与控制发作的药物同时服用。
凶险发作的抢救 凶险发作的抢救原则是:①迅速杀灭疟原虫无性体;②改善微循环,防止毛细血管内皮细胞崩裂;③维持水电平衡;④对症。
快速高效抗疟药 可选用:
青蒿素注射液 100mg肌注,第1天2次,后每天1次,疗程3日。
磷酸咯萘啶注射液 3~6ml/kg,加5%葡萄糖液或生理盐水静脉滴入或分次肌注,2~3天一疗程。
磷酸氯喹注射液 0.5g(基质 0.3g)加于5%葡萄糖液或生理盐水300~500ml 中,静滴。第1天内每6~8小时1次,共3次,第2、3日可再给1次。滴速宜慢,每分钟40滴以下。儿童剂量应小于5mg/kg/次,较安全为2.5mg/kg,滴速12~20滴/分。患者一旦清醒即改为口服。
二盐酸奎宁注射液 0.5g加于5%葡萄糖盐水或葡萄糖液300~500ml,缓慢静滴,8小时后可重复1次。儿童剂量5~10mg/kg/次,肝肾功能减退者应减少剂量,延长时隔时间。肌注应双倍稀释深处注入,以防组织坏死。
其它治疗 ①循环功能障碍者,按感染性休克处理,给予皮质激素,莨菪类药,肝素等,低分右旋糖酐;②高热惊厥者,给予物理、药物降温及镇静止惊;③脑水肿应脱水;心衰肺水肿应强心利尿;呼衰应用呼吸兴奋药,或人工呼吸器;肾衰重者可做血液透析;④黑尿热则首先停用奎宁及伯喹,继之给激素,碱化尿液,利尿等。
预防[编辑 | 编辑源代码]
要控制和预防疟疾,必须认真贯彻预防为主的卫生工作方针。部队进入疟区前,应及时做好流行病学侦察,针对疟疾流行的三个基本环节,采取综合性防治措施。
管理传染源 及时发现疟疾病人,并进行登记,管理和追踪观察。对现症者要尽快控制,并予根治;对带虫者进行休止期治疗或抗复发治疗。通常在春季或流行高峰前一个月进行。凡两年内有疟疾病史、血中查到疟原虫或脾大者均应进行治疗,在发病率较高的疫区,可考虑对15岁以下儿童或全体居民进行治疗。治疗方法见表。
切断传播途径 在有蚊季节正确使用蚊帐,户外执勤时使用防蚊剂及防蚊设备。灭蚊措施除大面积应用灭蚊剂外,量重要的是消除积水、根除蚊子孳生场所。
夏日防治疟疾
疟疾是由疟原虫引起的,疟原虫在医学上分间日疟原虫三日疟原虫、卵形疟原虫和恶性疟原虫四类。间日疟原虫和卵形疟原虫引起的疟疾,每隔一日发作一次,叫间日疟。三日疟原虫引起的疟疾每隔二日发作一次叫三日疟。恶性疟原虫引起的疟疾叫恶性疟疾,它发作频繁,无规律,严重时常有抽风、昏迷等症,如不及时治疗,病人可在短期内死亡。疟疾的传播媒介是按蚊,按蚊吸入疟疾病的血,再叮咬健康的人时,就会把它唾液中的疟原虫带进健康人的血液,使健康人发病。因此,防止疟疾要抓住积极治疗传染源(病人),彻底灭按蚊和搞好个人防护这三个基本环节。
1.积极治疗传染源。常用的药物主要有羟基喹哌、乙胺嘧啶、磷酸咯啶等。另外常山、青蒿、柴胡等中药治疟的效果也很好。以上这些药物要根据疟原虫的种类和病情的轻重由医生来对症使用,剂量和用法一般人不易掌握,千万不要自己乱吃。除此之外,还要对患者进行休止期治疗,即对上一年患过疟疾的人,再用伯氨喹啉治疗,给予8天剂,以防止复发。
2.彻底消灭按蚊。主要措施是搞好环境卫生,包括清除污水,改革稻田灌溉法,发展池塘、稻田养鱼业,室内、畜棚经常喷洒杀蚊药等。
3.搞好个人防护。包括搞好个人卫生,夏天不在室外露宿,睡觉时最好要挂蚊帐;白天外出,要在身体裸露部分涂些避蚊油膏等,以避免蚊叮。
保健[编辑 | 编辑源代码]
保护易感者
服药预防进入疟区,特别是流行季节,在高疟区必须服药预防。一般自进入疟区前2周开始服药,持续到离开疟区6~8周。下列药物可据条件酌情选用。
乙胺嘧啶 4片每周一次,或8片每两周一次。长期服用可致巨细胞性贫血,还可产生耐受性。(乙胺嘧啶每片6.25mg)。
哌喹或磷酸哌喹 服基质0.6g,每20~30天服1次。耐氯喹地区也可采用。
复方防疟药 防疟片1号,含乙胺嘧啶20mg,氨苯砜100mg,第1、2日每日片,以后每周1片。防疟片2号,每片含乙胺嘧啶17.5mg,周效磺胺250mg,第1、2日每日片,以后每10日片。防疟片3号,含磷酸哌喹250mg,周效磺胺50mg,每月1次,每次片。
氯喹2片,每10日1次,接受输血者可服氯喹每日(1片)基质0.15g,连服3~5日。
服用预防药物可出现一些副作用,如头晕、头昏、恶心、呕吐等,所以重症肝、心、肾疾病及孕妇应慎用或忌用。为防止耐药株产生,每3个月调换1次药物。
中医对疟疾的认识[编辑 | 编辑源代码]
疟疾,病名。简称为疟,出《素问.疟论》。以间歇性寒战、高热、出汗为特征的传染病。多发于夏秋季节及山林多蚊地带。《内经》又名痎疟,《金匮要略》名为疟病,《太平圣惠方》始有“疟疾”之名。发病多因风寒暑湿之邪客于营卫所致。多发于夏秋季节及山林多蚊地带。根据体质强弱、所感病邪流行特点及证候的不同分类。按临床证候分类有风疟、暑疟、湿疟、痰疟、食疟、寒疟、温疟、风热疟等。按发病时间分类,有间日疟、三日疟、正疟、子母疟、夜疟、鬼疟、暴疟、游疟、老疟、久疟、阴疟、阳疟等。按诱发因素及流行特点分类,有劳疟、虚疟、瘴疟、疫疟等。按脏腑、经络分类,有五脏疟、三阳经疟、三阴经疟等。除辨证用药外,可加用常山、草果、蜀漆、青蒿等,并可用针刺及穴位敷贴等。详见疟疾各条。
参看[编辑 | 编辑源代码]
| 根据香港法例第599章 《预防及控制疾病条例》疟疾(Malaria)为需呈报的传染病。 |
| 疟疾为中华人民共和国乙类法定传染病。 |
| 疟疾为台湾第二类法定传染病。 |
| |||||||||||||||||||||||||||||||||
| ||||||||||||||||||||||||||||||||||||||